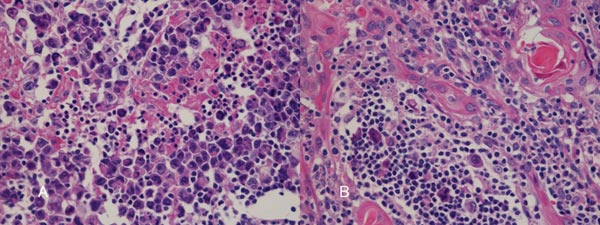
胸腺のホジキンリンパ腫 胸腺のホジキンリンパ腫

甲状腺と胸腺腫・胸腺過形成・胸腺癌・異所性胸腺・迷入胸腺・胸腺嚢胞(胸腺のう胞)[橋本病 バセドウ病 甲状腺機能亢進症 長崎甲状腺クリニック 大阪]
甲状腺:専門の検査/治療/知見① 橋本病 バセドウ病 甲状腺エコー 長崎甲状腺クリニック大阪
甲状腺専門の長崎甲状腺クリニック(大阪府大阪市東住吉区)院長が海外・国内論文に眼を通して得た知見、院長自身が大阪市立大学(現、大阪公立大学) 代謝内分泌病態内科で得た知識・経験・行った研究、日本甲状腺学会学術集会で入手した知見です。
長崎甲状腺クリニック(大阪)以外の写真・図表はPubMed等において学術目的で使用可能なもの(Creative Commons License)、public health目的で官公庁・非営利団体等が公表したものを一部改変しています。引用元に感謝いたします。尚、本ページは長崎甲状腺クリニック(大阪)の経費で非営利的に運営されており、広告収入は一切得ておりません。
甲状腺・動脈硬化・内分泌代謝に御用の方は 甲状腺編 動脈硬化編 甲状腺以外のホルモンの病気(副甲状腺/副腎/下垂体/妊娠・不妊など) 糖尿病編 をクリックください。
長崎甲状腺クリニック(大阪)は甲状腺専門クリニックです。胸腺腫/重症筋無力症の診療を行っておりません。
- 甲状腺と胸腺腫・CASTLE甲状腺癌(このページ)
- 甲状腺と重症筋無力症
Summary
甲状腺機能亢進症/バセドウ病の32%で胸腺過形成がおこり甲状腺機能正常化で縮小、重症筋無力症を伴うことも。上縦隔にできる胸腺腫は胸腺癌(悪性胸腺腫)の可能性から胸部外科手術になるため、MRIで脂肪成分を評価し必ず鑑別診断。甲状腺超音波エコー検査にて胸腺腫は甲状腺下の内部均一な腫瘤。小児の胸腺とは異なる見え方。甲状腺機能亢進症/バセドウ病、甲状腺機能低下症/橋本病に胸腺癌合併も。組織型は扁平上皮癌・未分化癌・小細胞癌と多様。胸腺腫は胸腺癌ともに縦隔の悪性リンパ腫・胚細胞腫瘍と鑑別を要する。胸腺嚢胞(胸腺のう胞)は偶然見つかる。
Keywords
甲状腺機能亢進症,バセドウ病,胸腺過形成,甲状腺,胸腺腫,胸腺癌,悪性胸腺腫,橋本病,鑑別,MRI
未治療甲状腺機能亢進症/バセドウ病患者の32%(3人に1人)で胸腺過形成(良性の胸腺細胞増殖、腫瘍の「胸腺腫」と異なる)による前縦隔腫瘍が合併する(Lancet1964;10:776-8)。
- 胸腺には甲状腺刺激ホルモン(TSH)低親和性のTSH受容体(TSH受容体アイソフォーム)が存在し、TSH受容体抗体(TRAb, TSAb)により胸腺上皮が増殖する
- 甲状腺ホルモン自体の作用により胸腺過形成が起こる(Clin Exp Immunol 1997;27 :516-21.)
ためと考えられます。
胸腺の過形成による前縦隔腫瘍は胸部レントゲンで写る事があり、肺CT/MRIで確認します。
治療開始後で間もない甲状腺機能亢進症/バセドウ病患者のCT写真を撮ると、3人に一人は胸腺過形成が見つかり、
- 「胸腺腫だ!大変だ!呼吸器外科に紹介だ!」と大騒ぎになる→腫瘍の「胸腺腫」と間違われて開胸手術されれば悲惨な事に
- 心臓の上に乗っかるような形態なので、左に多く、CTで見ると、あたかも左下極の甲状腺結節・甲状腺腫瘤・甲状腺腫瘍のように見えて、「内分泌内科に紹介だ!」「甲状腺外科に紹介だ!」と大騒ぎになる
エコーで見りゃ甲状腺の中でなく外なので分かりそうなもんだが、穿刺細胞診して「多数のリンパ球の中に角化した扁平上皮細胞を少数認め」ればリンパ濾胞性過形成[Lancet. 1964 Oct 10;2(7363):776-8.]と予想が付きます。
大抵の放射線科専門医は「CTで甲状腺の質的評価をしてはならない」という鉄則を知っていますが、経験の浅い医師が読影するとこのような事態になります。
年に1回は、こう言う話に巻き込まれ、「なんだ、またか・・・」と毎回思ってしまいます。しかし、
- 治療後、何年も経っている甲状腺機能亢進症/バセドウ病で見つかれば、本物の胸腺腫、胸腺癌(悪性胸腺腫)
- 胸腺過形成と高をくくっていても、おそらく1%未満の確率で本物の胸腺腫、胸腺癌(悪性胸腺腫)かもしれない
ので、見つけた以上、下記の様に鑑別診断せざる得ない。だが、筆者も今までバセドウ病合併「本物の胸腺腫」は2例しか見た事が無い。
ただ、甲状腺機能亢進症/バセドウ病に胸腺過形成を合併した場合、重症筋無力症を伴う可能性があるので要注意。甲状腺機能亢進症/バセドウ病と重症筋無力症は症状が似ています[重症筋無力症と甲状腺機能亢進症/バセドウ病、重症筋無力症と甲状腺眼症(橋本病眼症/バセドウ病眼症)]。[Neurol India. 2016 Jul-Aug;64(4):783-5.]
胸腺過形成は、
- 真性胸腺過形成
- 反応性胸腺過形成
- リンパ濾胞性胸腺過形成
に分類されます。
このうち、リンパ濾胞性胸腺過形成は甲状腺機能亢進症/バセドウ病、橋本病(慢性甲状腺炎)、全身性エリテマトーデス(SLE)、ベーチェット病等に合併します。
胸腺腫は胸腺癌(悪性胸腺腫)の可能性があるため、経過観察は難しく、侵襲の大きい胸部外科手術になりますが、止む得えません。しかし、胸腺過形成は甲状腺機能が正常化すると縮小し、消失することもあるため経過観察のみで可です。不必要な大手術を避けるためにも胸腺腫と胸腺過形成は鑑別しなければなりません。
胸腺過形成 CT画像 (JBR–BTR 2012, 95 281-288)
前縦隔に造影効果のある軟部濃度腫瘤を認め、胸腺腫瘍に特徴的な"へ"の字型形態です。
最も鑑別を要する胸腺腫はMRIで内部が不均一に描出される率が高いが、胸腺過形成は内部が均一に描出される(臨床放射線1995;40:825-30)
CTやMRIにおいて、①腫瘤内部に脂肪成分を含むため、まだら状の小結節性低吸収域が見られる、②MR脂肪抑制像(化学シフトMRイメージング)で正常胸腺と同じ生理的な脂肪成分が存在すれば胸腺過形成(Radiology2007;243:869-76)。
脂肪成分を含まない胸腺腫や胸腺癌(悪性胸腺腫、浸潤性胸腺腫)と鑑別されます。
治療により甲状腺機能が正常化すると胸腺過形成も縮小する症例が数多くあります。筆者が調べたところ、
- 19-52歳の女性
- 胸腺は6×20mm~18×52mm~75×100mmと様々だが、かなり大きい
- 甲状腺機能亢進症/バセドウ病の治療開始後3-9カ月して胸腺は縮小傾向、全症例が消失する訳で無く、15カ月で消失する症例もある
[Intern Med. 2022 Sep 15;61(18):2753-2757.][J Endocrinol Invest. 2014 Dec;37(12):1175-9.](日呼外会誌 24(1),2010,69-73)(日呼外会誌 21(1),2007,43-47)(第56回 日本甲状腺学会 P1-100 抗甲状腺薬治療に伴う前縦隔腫瘍の縮小経過を追跡し得たバセドウ病の2 例)
一過性の甲状腺中毒症である無痛性甲状腺炎でも一過性胸腺過形成をおこした報告があります。甲状腺ホルモン自体の作用 が一因と考えられます(Clin Exp Immunol 1997;27 :516-21.)。同時に回盲部・鼠径部リンパ節腫大を認めた事から、リンパ濾胞様の過形成が胸腺にも生じたと考えられます。
薬剤性などを除く無痛性甲状腺のほとんどが、橋本病(慢性甲状腺)の亜急性増悪であり、リンパ節腫大を伴う事が多いため、胸腺過形成をおこしても不思議はありません。(第60回 日本甲状腺学会 P2-3-6 甲状腺中毒症に胸腺腫大を合併した2例)
[Med Leg J. 2017 Jun;85(2):111-112.][Endocrinol Diabetes Nutr (Engl Ed). 2023 Jan;70(1):65-67.]
胸腺腫
成人になるにつれて退化する胸腺細胞から胸腺腫が発生します。心臓の前上部、前縦隔にできます。
胸腺腫には、
- リンパ球優位型
- 混合型
- 上皮細胞集塊型
があり、上皮細胞集塊型は悪性度が高いとされます。多発性内分泌腺腫症1型(MEN1)に発生する胸腺腫瘍は悪性度が高く、早期に骨・肝臓に転移します。
胸腺腫には、自己免疫性疾患
を合併する場合があります。
甲状腺超音波(エコー)上、胸腺腫は甲状腺の下に見え、内部不均一な腫瘤で、特徴的な所見に欠きます。小児の胸腺とは異なる見え方です。
心臓の上に乗っかるような形態なので、左に多く、CTで見ると、あたかも甲状腺結節・甲状腺腫瘤・甲状腺腫瘍のように見えます。
胸腺癌(悪性胸腺腫、浸潤性胸腺腫)
胸腺癌(悪性胸腺腫、浸潤性胸腺腫)は非常に稀で、標準的な治療が存在しません。組織型も、扁平上皮癌・未分化癌・小細胞癌と多様です。甲状腺機能亢進症/バセドウ病に合併した
- 胸腺癌(Thyroid Res. 2012 Jul 23;5(1):5.)
- 胸腺原発非定型的カルチノイド(Well differentiated neuroendocrine carcinoma、Atypical carcinoid)(第56回日本甲状腺学会 P1-085 メルカゾール投与後に蕁麻疹様血管炎を生じ、131I 治療の2年半後に胸腺原発異型カルチノイドと診断されたバセドウ病の1 例)
などが報告されています。
長崎甲状腺クリニック(大阪)では甲状腺機能低下症/橋本病に合併した胸腺癌(悪性胸腺腫、浸潤性胸腺腫)の自験例があります。
胸腺癌(悪性胸腺腫、浸潤性胸腺腫)は前胸部から肺門部まで浸潤し、横隔神経自体にも浸潤するため、摘出手術で横隔神経を損傷する可能性が高い(術後横隔神経麻痺)。術後横隔神経麻痺では、術後から息が深く吸えなくなります。内肋間筋・補助呼吸筋と代償性の呼吸数増加で補える場合が多いが、重症例は胸腔鏡下横隔膜縫縮術の適応。
術後横隔神経麻痺は、特に浸潤性の強い甲状腺癌、前縦隔に浸潤する甲状腺癌(甲状腺未分化癌 甲状腺原発扁平上皮癌 など)の切除手術後にも起こります。
胸腺腫/胸腺癌(悪性胸腺腫)と鑑別を要する縦隔の悪性リンパ腫・縦隔の胚細胞腫瘍
縦隔の悪性リンパ腫
胸腺腫/胸腺癌(悪性胸腺腫)は、少なからずリンパ組織の増殖を認めるため、sIL2-R (可溶性インターロイキン2受容体) 高値となり、縦隔の悪性リンパ腫と鑑別を要します。また、胸腺に発生する悪性リンパ腫は、胸部外科で開胸生検で鑑別するしかないでしょう。
縦隔に発生する悪性リンパ腫は、
- ホジキンリンパ腫(甲状腺悪性リンパ腫では、ほとんど見られない)
- T細胞性リンパ芽球型リンパ腫(甲状腺悪性リンパ腫では、ほとんど見られない)
- 縦隔原発大細胞型B細胞性リンパ腫(甲状腺原発悪性リンパ腫でもよく見られる)
- 節外性粘膜関連濾胞辺縁帯リンパ腫(MALTリンパ腫)(甲状腺原発悪性リンパ腫でもよく見られる)
などがあります。
縦隔の胚細胞腫瘍
胸腺腫/胸腺癌(悪性胸腺腫)と鑑別を要する縦隔の胚細胞腫瘍。
胸腺嚢胞(胸腺のう胞)は、胎生期における胸腺鰐管や胸腺咽頭管の遺残、迷入鰐弓由来の先天性嚢胞です。やや女性に多い。
胸腺嚢胞(胸腺のう胞)は、ほとんどが無症状で、偶然、肺CTなどで発見されるケースが多い。内分泌領域においては、甲状腺癌の肺転移や甲状腺腫瘍の縦隔進展(縦隔内甲状腺腫)の評価時に行う胸部肺CTで見つかります。
[Histopathology. 2024 Jan;84(1):183-195.]
頸部の異所性胸腺嚢胞(胸腺のう胞)はまれであり、甲状腺内胸腺嚢胞(胸腺のう胞)はさらにまれです。甲状腺内に発生した多房増殖性胸腺嚢胞(胸腺のう胞)の報告があります。[Endocr Pathol. 2015 Mar;26(1):45-7.]
ナトリウム-ヨードシンポーター(NIS)を発現し、放射性ヨウ素(I-131)が集積した頸部異所性胸腺嚢胞(胸腺のう胞)の報告もあります。[Medicine (Baltimore). 2022 Jul 1;101(26):e29282.]
前縦隔の胚細胞腫瘍
甲状腺腫と鑑別を要する縦隔の胚細胞腫瘍は
- 奇形腫
- 精上皮腫
- 胎児性癌
などです。
また、きわめて稀ですが、パラガングリオーマが発生する場合があります。パラガングリオーマは、頭蓋底・頸部・胸部・膀胱付近などの傍神経節に発生する腫瘍(傍神経節腫)です。交感神経由来のパラガングリオーマは、カテコラミン(アドレナリン、ノルアドレナリン、ドーパミンなど)を過剰産生する場合が多く、副交感神経由来のパラガングリオーマはホルモン産生しないことが多いです。副腎に発生しカテコラミンを過剰分泌する腫瘍は褐色細胞腫で、副腎以外の傍神経節に発生するのがパラガングリオーマと呼ばれます。[Kyobu Geka. 2019 Feb;72(2):108-111.][Ann Thorac Surg. 1994 Jan;57(1):249-52.]
奇形腫
手塚治虫のブラックジャックで有名な奇形腫。内部に歯・皮脂などを含み、エコーで内部不均一に見えます。むしろCTの方が、内部の成分を明瞭に鑑別できます。
甲状腺関連の上記以外の検査・治療 長崎甲状腺クリニック(大阪)
- 甲状腺編
- 甲状腺編 part2
- 内分泌代謝(副甲状腺/副腎/下垂体/妊娠・不妊等
も御覧ください
長崎甲状腺クリニック(大阪)とは
長崎甲状腺クリニック(大阪)は日本甲状腺学会認定 甲状腺専門医[橋本病,バセドウ病,甲状腺超音波(エコー)検査など]による甲状腺専門クリニック。大阪府大阪市東住吉区にあります。平野区,住吉区,阿倍野区,住之江区,松原市,堺市,羽曳野市,八尾市,生野区,東大阪市,天王寺区,浪速区も近く。